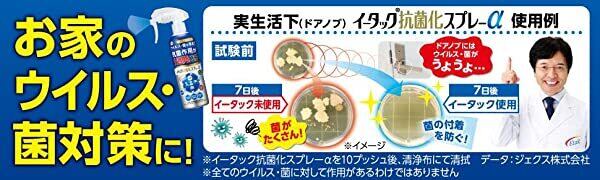

エーザイ イータック抗菌化スプレーα 250mL ★日本製 ★ウイルス・菌が気になるところにシュッ!とスプレー。ウイルス・菌を寄せ付けない。抗菌作用が1週間持続
¥1,408 税込
残り1点
なら 手数料無料で 月々¥460から
別途送料がかかります。送料を確認する
¥11,000以上のご注文で国内送料が無料になります。
商品コード 4987028178934
ウイルス・菌が気になるところにシュッ!とスプレー。ウイルス・菌を寄せ付けない。抗菌作用が1週間持続。ノンアルコールタイプ
【商品説明】
・ドアノブやテーブルなど、気になるところにスプレーすることで、Etak®(持続型抗菌成分イータック)によりウイルスや菌を寄せ付けません。
・赤ちゃん用品やペットの身の回り用品にも使用できます。Etak®(イータック)は抗菌成分が対象物表面に固定されるため、スプレーした直後の抗菌作用だけでなく、乾燥した後も抗菌作用が1週間持続します。
※全てのウィルス、菌に対して効果があるわけではありません。
※使用状況によっては持続力が異なります。
※効果は噴霧液がついた部分に限られます。
※本品は医薬品、医薬部外品ではありません。
お家のウイルス・菌対策!イータック抗菌化スプレーα
https://www.eisai.jp/etak/lp_etak2.html
《 Point 》
・気になるところに「シュッ」として「サッ」と拭くことで、ウィルス・菌を除去、抗菌作用が1週間持続します。
・安全性試験評価済み。
※皮膚一次刺激性試験、眼刺激性試験。
・無香料・無着色のノンアルコールタイプです。塩素系成分不使用。
・菌による気になるニオイを抑えます。
・使用後は「つめかえ用」を本体ボトルにつめかえてご使用いただけます。
・Etak®は、特許取得の持続型抗菌成分です。(特許番号第4830075号)
【使用方法】
・ご使用時はストッパーを外してください。ストッパーを戻すとロックされます。
・噴霧口を対象に向け約20~30cmほど離して適量をスプレーしてください。
※ 使い始めはレバーを最後までしっかり引くように複数回空押ししてください。
※ 均一に塗布させるためには布などで拭き広げてください。
※ 本品を逆さ向きに使用しないでください。
【成分】
水、エトキシシラン系化合物(持続型抗菌成分)、可溶化剤、安定化剤
【使用上の注意】
●本品の使用により過敏症状があらわれた場合には使用を中止し、医師にご相談ください。
●目に入らないように注意してください。万一入った場合はこすらずに、水、またはぬるま湯で十分洗い流し、医師に相談してください。
●鏡、精密機器、貴金属への使用は避けてください。
●気になる際は、目立たない所で試してからご使用ください。
●用途以外には使用しないでください。
●吸入しないように気をつけてください。
●直射日光の当たらない涼しいところに保管してください。
●小児の手の届かないところに保管してください。
●他の容器には詰め替えないでください。
【包装】
本体ボトル:250mL (約800プッシュ)
【発売元】
エーザイ株式会社
東京都文京区小石川4-6-10
【お問い合わせ先】
☎︎ 0120-151-454
(平日 9:00~18:00、土日・祝日 9:00~17:00、365日対応)
-
レビュー
(41)
-
送料・配送方法について
-
お支払い方法について
¥1,408 税込